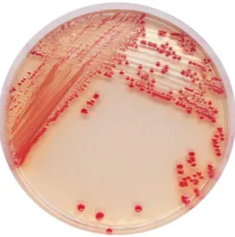
CHROMagar™ Acinetobacter
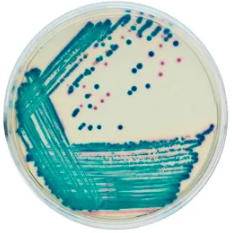
CHROMagar™ C3GR
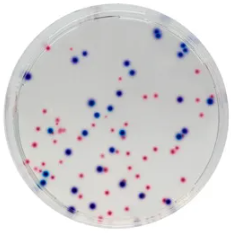
CHROMagar™ CCA
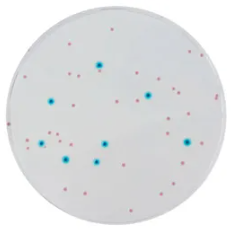
CHROMagar™ Enterobacteria
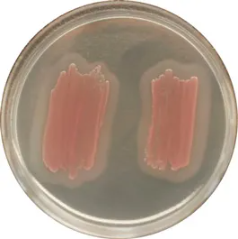
CHROMagar™ Identification Listeria
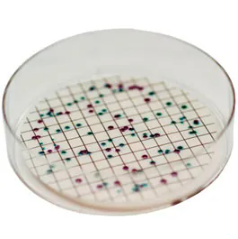
CHROMagar™ Liquid ECC
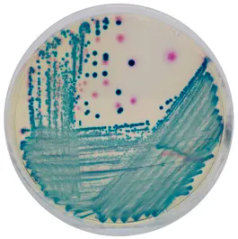
CHROMagar™ mSuperCARBA™
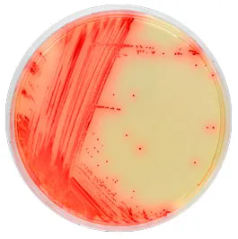
CHROMagar™ Mycoplasma
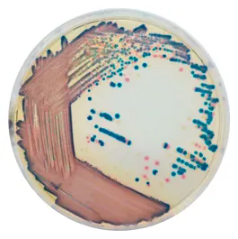
CHROMagar™ COL-APSE
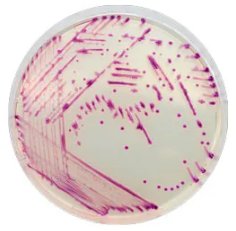
CHROMagar™ Pasteurella
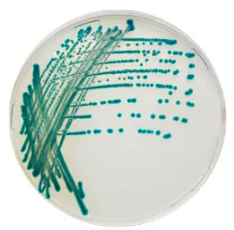
CHROMagar Serratia
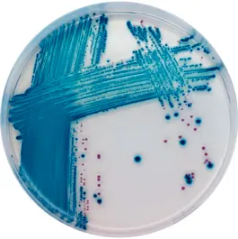
CHROMagar™ STEC

Chromogenic Chromagar™ táptalajok
Ár kérése
A kromogén táptalajok a mikrobiológiában használt speciális táptalajok, amelyek a mikroorganizmusok azonosítására szolgálnak a képződött telepek színe alapján. A szín a táptalajban lévő anyagokból származik, amelyek kölcsönhatásba lépnek az azonosítandó mikroorganizmus(ok) specifikus anyagcsereútjaival.
A CHROMagar™ kromogén táptalajtechnológia innovatív kromogén táptalajmegoldásokat kínál, amelyek célja a hagyományos tenyésztési technikák fejlesztése és egyszerűsítése azáltal, hogy megkönnyítik az érdekes baktériumtörzsek vizuális azonosítását 18-24 órán belül.
| Típus | Leírás |
|---|---|
| AquaCHROM™ ECC | Agar nélküli kromogén táptalaj kólibaktériumok és E. coli egyidejű kimutatására 100 ml vízben. Nincs szükség UV lámpára. |
| CHROMagar™ Acinetobacter | Dehidratált kromogén táptalaj Acinetobacter spp. kimutatására. |
| CHROMagar™ B. cereus | Dehidratált kromogén táptalaj Bacillus cereus kimutatására és számlálására környezeti és élelmiszermintákban. Nincs szükség tojássárgája emulzió hozzáadására. |
| CHROMagar™ C3GR | Kromogén táptalaj széles spektrumú béta-laktamázt termelő Gram-negatív baktériumok egy éjszakán át történő kimutatására. A termék por alapból (CHROMagar Orientation) és 1 kiegészítőből (CHROMagar C3GR kiegészítő) áll. |
| CHROMagar™ Campylobacter | Dehidratált kromogén táptalaj termotoleráns Campylobacter kimutatására, differenciálására és számlálására. |
| CHROMagar™ Candida | Dehidratált kromogén táptalaj a klinikailag jelentős fő Candida fajok izolálására és differenciálására. |
| CHROMagar™ CCA | Kromogén coliform agar ß-glükuronidáz-pozitív E. coli és coliform baktériumok kimutatására és számlálására alacsony bakteriális háttérflórájú vízben (az ISO 9308-1 szabvány szerint). |
| CHROMagar™ C. difficile | Fluorogén dehidratált táptalaj, amely rendkívül érzékeny és szelektív a Clostridium difficile izolálására és közvetlen megkülönböztetésére. |
| CHROMagar™ C. perfringens | Kromogén dehidratált táptalaj a Clostridium perfringens kimutatására és számlálására. |
| CHROMagar™ ECC | Kromogén dehidratált táptalaj az E. coli és más coliform baktériumok egyidejű kimutatására és számlálására élelmiszer- és vízmintákban. |
| CHROMagar™ E. coli | Kromogén dehidratált táptalaj az E. coli kimutatására és számlálására élelmiszer- és vízmintákban. |
| CHROMagar™ Enterobacteria | Kromogén táptalaj az Enterobacteriaceae kimutatására és számlálására. |
| CHROMagar™ ESBL | Kromogén táptalaj széles spektrumú béta-laktamázt termelő Gram-negatív baktériumok éjszakán át történő kimutatására. A termék por állagú alapból (CHROMagar Orientation) és 1 kiegészítőből (CHROMagar ESBL kiegészítő) áll. |
| CHROMagar™ Identification Listeria | Kromogén táptalaj L. monocytogenes fajok megerősítésére gyanús telepekből CHROMagar Listeria táptalajról. A táptalajjal (Cikkszám: 00000LM852, CHROMagar™ Listeria) kombinálva lehetővé teszi az L. monocytogenes egyszerű megerősítését 2 nap alatt. |
| CHROMagar™ KPC | Kromogén táptalaj a legtöbb karbapenem szerrel szemben csökkent érzékenységű Gram-negatív baktériumok kimutatására. A termék por állagú alapból (CHROMagar Orientation) és 1 kiegészítőből (CHROMagar KPC kiegészítő) áll. |
| CHROMagar™ Liquid ECC | Kromogén dehidratált táptalaj az E. coli és más coliformok egyidejű kimutatására és számlálására vízmintákban. |
| CHROMagar™ Listeria | Kromogén dehidratált táptalaj a Listeria monocytogenes kimutatására, megkülönböztetésére, számlálására és megerősítésére más baktériumoktól élelmiszermintákban. |
| CHROMagar™ Malassezia | Kromogén dehidratált táptalaj a Malassezia spp. kimutatására. |
| CHROMagar™ Mastitis | Kromogén táptalaj a mastitis fertőzésekben részt vevő baktériumok gyors és egyszerű megkülönböztetésére (készlet 2 különböző kromogén táptalajt tartalmaz, egyet más Gram-pozitív baktériumokhoz és egyet Gram-negatív baktériumokhoz). |
| CHROMagar™ MH Orientation | Mueller Hinton kromogén táptalaj |
| CHROMagar™ MRSA | Kromogén dehidratált táptalaj a meticillin-rezisztens Staphylococcus aureus (MRSA), beleértve az alacsony szintű MRSA-t is, izolálására és megkülönböztetésére. |
| CHROMagar™ mSuperCARBA™ | Kromogén táptalaj a karbapenemázt termelő Enterobacteriaceae (CPE) kimutatására és izolálására. A termék egy por állagú alapból (B) és 2 kiegészítőből áll: S1 (növekedési faktorok keveréke) + S2 (szelektív keverék). |
| CHROMagar™ Mycoplasma | Kromogén táptalaj a Mycoplasma bovis kimutatására |
| CHROMagar™ COL-APSE | Kromogén dehidratált táptalaj a kolisztin-rezisztens Gram-negatív baktériumok kimutatására. |
| CHROMagar™ O157 | Kromogén dehidratált táptalaj az E. coli O157 szelektív izolálására és differenciálására klinikai és élelmiszermintákban. A szorbitol MacConkey agar táptalaj alternatívája. A táptalaj szelektivitása kálium-tellurit hozzáadásával növelhető. |
| CHROMagar™ Orientation | Kromogén dehidratált táptalaj a húgyúti kórokozók izolálására és differenciálására. Általános táptalajként is használható kórokozók izolálására. |
| CHROMagar™ Pasteurella | Kromogén táptalaj Pasteurellaceae kimutatására |
| CHROMagar™ Pseudomonas | Kromogén dehidratált táptalaj Pseudomonas spp. izolálására és kimutatására. Membránszűréses technikához alkalmazható. |
| CHROMagar™ Salmonella | Kromogén dehidratált táptalaj Salmonella kimutatására és izolálására. |
| CHROMagar™ Salmonella Plus | Kromogén dehidratált táptalaj Salmonella fajok, beleértve a laktóz-pozitív Salmonellát is, kimutatására és izolálására élelmiszermintákban az ISO 6579 szabvány szerint. |
| CHROMagar Serratia | Kromogén táptalaj Serratia marcescens kimutatására |
| CHROMagar™ Staph aureus | Kromogén dehidratált táptalaj Staphylococcus aureus izolálására és közvetlen differenciálására. |
| CHROMagar™ Staphylococcus | Kromogén dehidratált táptalaj Staphylococcus spp. kimutatására és izolálására. |
| CHROMagar™ Strep B | Kromogén dehidratált táptalaj Streptococcus agalactiae (GBS) izolálására és differenciálására. |
| CHROMagar™ Streptococcus | Kromogén dehidratált táptalaj Streptococcus spp. kimutatására és izolálására. |
| CHROMagar™ STEC | Kromogén dehidratált táptalaj Shiga-toxint termelő E. coli (STEC) kimutatására. |
| CHROMagar™ Vibrio | Kromogén dehidratált táptalaj V. parahaemolyticus, V. vulnificus és V. cholerae izolálására és kimutatására. |
| CHROMagar™ VRE | Kromogén dehidratált táptalaj Van A / Van B VRE.faecalis és VRE.faecium kimutatására. |
| CHROMagar™ Yersinia enterocolitica | Kromogén dehidratált táptalaj patogén Yersinia enterocolitica kimutatására és közvetlen differenciálására. |
| RAMBACH™ Agar | Kromogén dehidratált táptalaj Salmonella fajok kimutatására és izolálására klinikai és élelmiszermintákban. |
| RambaQUICK™ Salmonella | Dúsító táptalaj Salmonella fajok gyors kimutatására. |
Ajánlatkérés
Kapcsolódó termékek
2026 | Design és fejlesztés: Make It Online

 Belépés / Regisztráció
Belépés / Regisztráció